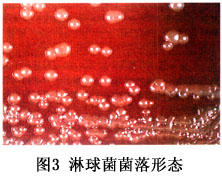
圖3

流行病學
 淋球菌性腹膜炎 表1
淋球菌性腹膜炎 表1人體對淋球菌有易感性是其惟一的天然宿主淋球菌感染者為淋病的傳染源。易感人群主要是性活躍的中青年人尤其是有多個性伴的人。對於淋菌性腹膜炎而言女性患病多於男性,平均年齡26歲。淋球菌腹膜炎的感染途徑有以下兩種:
1.直接擴散感染 泌尿生殖系直腸等腹腔器官的淋球菌感染通過生殖道蔓延和淋巴液回流直接擴散至腹腔,感染腹膜。成年患者多為此種感染。
2.血液傳播 咽部、直腸和眼結膜等部位的淋球菌原發性感染灶,在機體免疫力降低時,其淋球菌進入血液循環隨血流移至腹腔,感染腹膜。
淋病為一種古老的性病,在世界範圍內流行已久。在西方大多數國家,經過二戰和70年代初期兩個發病高峰其發病率呈逐年下降趨勢。從1977~1999年,美國報導的淋病病例數下降56%,從每年100萬下降至43.9萬,發病率由 468/10萬下降至176/l0萬。丹麥淋病病例數在1984年為10395例,1996年降低為178例。自70年代末性病在中國再度傳入後,淋病為首次報導的性病,其發病率逐年上升,為中國目前流行的主要性病,但在各種性病中的構成比呈下降趨勢(表1)。
病因
 圖1
圖1淋球菌性腹膜炎多繼發於患者自身其他部位的淋球菌感染如急性盆腔腹膜炎,大多數繼發急性淋球菌性輸卵管炎,輸卵管滲出物經傘端流入腹腔引起局限性盆腔的炎症;急件原發性淋菌件腹膜炎,是由陰道淋菌播散引起;急性彌散性腹膜炎則由於輸卵管淋球菌積膿卵巢淋球菌膿腫或盆腔淋球菌膿腫破裂而引起。
淋球菌性腹膜炎的病原體為淋病雙球菌,系1879年奈瑟氏所發現故又名奈瑟淋病雙球菌(Neisseria gonorrhoeae) 呈卵圓形或腎形,成對排列,其大小0.6~0.8µm,一股存於多形核白細胞的胞漿內,革蘭染色陰性;普通培養基上不生長,可在3%~10%CO2條件下用朱古力血液瓊脂培養基或含有萬古黴素、黏菌素及制黴菌素的Thayer-Martln培養基方能生長。
發病機制
 圖2
圖2人類是淋球菌的惟一天然宿主,主要侵襲黏膜組織並引起局部炎症性反應:廣泛充血、水腫、漿液性滲出,繼而化膿,結締組織增生。
淋球菌感染機體涉及不同的階段包括黏附、侵入、細胞內生存及誘導宿主反應等。體外組織及器官培養研究表明,淋球菌通過多種黏附素黏附於非纖毛上皮細胞,通過一種涉及肌動生蛋白微絲和微管的內在化作用(internalization)進入上皮細胞經穿胞(transcytosis)和胞吐(exocytosis)通過基底層進入上皮下層。淋球菌通常定居上皮下層,誘發炎症反應,偶爾細菌進入血流引起播散性感染。在感染及傳播過程中淋球菌需適應宿主環境,逃避宿主的防禦機能。淋球菌適應及免疫逃避的機制包括表面成分的抗原變異、利用宿主成分、以及抵抗不利環境及吞噬細胞的攻擊。
淋球菌的主要毒力因子包括:
1.菌毛 具有相和抗原變異的能力,菌毛參與淋球菌的黏附及侵入,並為宿主免疫防禦的靶目標。
2.孔蛋白(PorB) 在淋球菌侵入、細胞記憶體活、血清抗性及抗生素敏感性中具重要作用。
3.不透明蛋白(Opa) 介導對幾種不同真核細胞的黏附與侵入。
4.Rmp蛋白 有很強的免疫原性、其抗體可阻斷正常及免疫血清對淋球菌的殺傷作用、在播散性淋球菌感染中具重要意義Rmp還參與淋球菌侵入上皮細胞。
5.脂寡糖(Los) 除參與各種生理性膜功能外,影響細菌的黏附與侵入、誘導炎症反應以及抵抗宿土的防禦。
6.IgAl蛋白酶 淋球菌分泌的一種細菌外肽鏈內切酶,以人血清型及分泌型IgAl為底物。最近研究表明,IgA2蛋白酶對淋球菌在細胞記憶體活上十分重要。
臨床表現
圖3
圖31.下腹痛 單側或兩側下腹部疼痛,少數為轉移性下腹部疼痛,但較其他腹膜炎輕常尿頻尿急尿痛、尿道灼痛,既往在半年內常有類似症狀。有不潔性接觸病史
2.腹膜刺激征 觸診腹部壓痛,以下腹部或右下腹為主,有反跳痛,腹肌緊張明顯。
3.後穹隆飽滿 急性盆腔腹膜炎時婦科檢查可有劇烈觸痛後穹隆飽滿,子宮頸活動性差,附屬檔案觸及炎性腫塊以右側明顯。
併發症:
淋球菌可隨血流到達全身,引起播散性淋球菌感染,如淋球菌性關節炎、
淋球菌性皮炎淋球菌性腱鞘炎、淋球菌性心內膜炎、淋球菌性腦膜炎和淋菌性肝周圍炎等。
診斷
急性淋病診斷標準:
1.病史 身體其他部位有明確的淋球菌感染史,或有不潔性交史,或配偶有淋球菌感染史,或患兒父母有淋球菌感染史,或與家中淋病患者共用物品史等。
2.臨床表現 有泌尿或生殖器官的感染症狀,如尿道口紅腫、膿性分泌物(或膿性白帶);有尿頻、尿急、尿痛等膀胱刺激征。有腹痛腹部壓痛、反跳痛、肌緊張等腹膜刺激征;全身不適等
3.實驗室檢查 分泌物鏡檢可見多形核白細胞內有革蘭染色陰性的雙球菌;選擇性培養基上分離出革蘭陰性,氧化酶陽性的雙球菌。
檢查
實驗室檢查:
1.外周血象 白細胞計數>15×109/L,中性粒細胞增多。
2.細菌學檢查
(1)分泌物鏡檢:
①尿道(男性)或陰道分泌物鏡檢:可有大量紅色多形核白細胞。在有些細胞中吞噬有淋球菌。淋球菌為革蘭陰性,呈卵圓形或圓形,常成雙排列兩菌接觸面扁平或稍凹菌體長約0.7µm,寬約0.5µm。但兩菌大小可有差異。多數多形核白細胞中並不含淋球菌但不少白細胞中常含有1對至數對,甚至數十對淋球菌。淋球菌常位於細胞質內(圖1)。
病期較長或經過治療的淋病患者,其分泌物塗片中淋球菌數目較少,有時呈單個、四聯和八疊狀且常位於細胞外(圖2)
尿道分泌物標本製作法:用浸有滅菌等滲鹽水的拭子揩洗尿道口,然後用手指由後向前擠出膿液,用棉拭子蘸取膿液後輕輕塗布於載玻片上待自然乾燥後加熱固定,染色(常用革蘭染色也可用亞甲藍染色),鏡檢。
②腹腔分泌物檢查:腹腔穿刺抽液膿液呈黃白色、稀薄、量少,無臭味塗片可找到淋病雙球菌或PCR球菌,DNA檢查陽性。
③注意事項:
A.淋病的診斷標準是可見“細胞內革蘭陰性雙球菌”,故塗片宜動作輕柔,且棉拭子不得在玻片上滾動,以防止細胞破裂或變形,細菌從細胞內逸出,造成診斷上的混淆
B.塗片薄厚適當。塗片過厚易造成脫色時間不足,使革蘭陰性菌也呈現紫色。大量染片時,最好用已知的革蘭陽性菌(如葡萄球菌)和陰性菌(如大腸埃希菌)作對比觀察。
C.固定塗片時,只需迅速通過火焰2~3次即可,避免加熱過度致細胞變形一般塗片至手背之上以不感到太燙為宜。
(2)淋球菌培養:淋球菌培養是WHO推薦的淋病篩查的惟一方法,也是診斷的“金標準”。
常用血液瓊脂或朱古力瓊脂培養基培養。為抑制雜菌,可加入適量抗菌物質,如多黏菌素B(25µg/ml)和萬古黴素(3.3µg/ml)等。
淋球菌在血平皿上經24~48h的培養後,可形成圓形、凸起、濕潤、光滑半透明或灰白色菌落邊緣呈花瓣狀,直徑為0.5~1.0mm,用接種環觸之有黏性(圖3)。如繼續培養,菌落面積增大表面變得粗糙,邊緣出現皺縮。若從菌落上取材作塗片,可見到菌的大小及染色的深度有差異,排列也不一致,約有25%的菌為典型的雙球菌,其他75%為單球菌、四聯形或八疊形。
使用液體培養基時,淋球菌生長於液體表面稍有輕度混濁和顆粒沉澱。
培養標本採集和送檢中應注意:
①深部取材:從男性尿道取材時,應將細小棉拭子伸入到尿道內2~4cm處,取出帶有黏膜細胞的分泌物。從女性宮頸取材時,應先用溫水濕潤擴陰器(不要用液體石蠟等潤滑油),然後將棉拭子插入宮頸管1.0~1.5cm,轉動並停留10~30s。有時為了提高陽性率,可同時取2份標本進行培養,但工作量也相應增加。
②及時送檢、接種:淋球菌對環境變化敏感,耐寒耐乾的能力弱。因此標本離體後要立即送檢若實驗室較遠,可將標本接種於Stuart或Amies運送培養基或浸入1%葡萄糖肉液浸中,途中保溫。
(3)氧化酶試驗:是淋球菌重要的初步診斷試驗之一。淋球菌在生長過程中能產生氧化酶。在經24~48h培養的菌落上滴加氧化酶試劑(0.5%~1%鹽酸二甲基對苯二胺或鹽酸四甲基對苯二胺水溶液),其菌落變成紫紅乃至黑色者為陽性反應。但氧化酶試驗陽性者並不完全是淋球菌。
為保證氧化酶試驗結果的準確性,操作中應注意3個問題:
①氧化酶試劑要新鮮:正常的氧化酶試劑(鹽酸二甲基對苯二胺或鹽酸四甲基對苯二胺)為淡紅色。若試劑變成灰色或黑色,說明已經失效。配製的試劑溶液需放在棕色玻璃瓶中避光保存有效使用時間約1周。
②避免使用鐵質接種環:氧化酶試劑與鐵離子接觸會產生紅色的化學變化,造成“陽性”假象,故淋球菌接種應避免使用舊鐵絲或電爐絲等製成的接種環。試驗前亦應檢查接種環與試劑接觸是否有紅色出現。
③需要保留菌種時,應在菌落尚未完全變黑時挑出少許轉種。菌落一旦變黑,多數細菌即告死亡。
(4)過氧化氫酶試驗:淋球菌可產生過氧化氫酶該酶能使過氧化氫迅速分解成水和氧氣,出現氣泡。用作淋球菌的初步鑑定。
①方法:用接種環挑取一菌落置於乾淨載玻片上,取30%(V/V)過氧化氫溶液1滴加於可疑菌落表面,在1s內有大量氣泡產生,為陽性反應。如反應遲緩或產生氣泡弱為陰性反應。
②注意:某些非致病的奈瑟菌亦可為陽性反應。陰性反應可除外淋球菌。
(5)直接免疫螢光試驗:將螢光素標記的淋球菌抗血清(單克隆抗體)滴於可疑菌上遇到淋球菌(抗原)時,抗體與抗原結合,在螢光顯微鏡下可見到發蘋果綠色螢光的菌體。本法檢測快速死菌亦可有陽性反應
(6)酶反應:淋球菌具有特殊的酶類,能使某些酶的產色底物顯色,據此與其他奈瑟菌區別開來臨床用於淋球菌鑑定。
其它輔助檢查:
選擇做腹部B超及腹平片檢查。
相關檢查:
脫氧核糖核酸染色
治療
1.非手術治療
(1)全身抗生素治療:首選青黴素,480萬~1000萬U/d靜滴加諾氟沙星(氟哌酸)0.6g/d,用3~5天。或青黴素加甲硝唑靜滴;頭孢曲松(頭孢三嗪菌必治)2g,加入40ml葡萄糖液內靜注,共7天;紅黴素加慶大黴素等。
(2)局部抗生素治療:腹膜炎嚴重者可用0.5%甲硝唑溶液100ml及頭孢曲松1.0g,1次/d腹腔內注射,交替套用。
(3)配偶或性伴侶應同時治療
2.手術治療
(1)適應證:瀰漫性腹膜炎伴全身中毒症狀者;非手術治療無效者;腹內炎性腫塊者;病情危重,難以排除其他外科急腹症者。
(2)手術方法:剖腹探查術或腹腔鏡探查術。術中吸淨腹內膿液,行徹底沖洗,並置雙套管引流。
預防
淋病主要是通過性交直接傳播的疾病淋球菌性腹膜炎多繼發於其他部位的淋球菌感染。因此預防工作必須從基本環節做起。
1.提倡健康的性生活習慣,改變不良的性行為, 避免非婚性接觸。
2.建議性生活中應使用安全套,以預防淋病的交叉感染。
3.生活用品要專用如洗浴毛巾、內褲、清洗盆等,以避免淋球菌感染時引起家庭內傳播。
4.家庭中患有急性淋病者應進行相應的隔離治療。如避免性生活對清洗盆、內褲洗浴毛巾等進行消毒處理,並對1個月內的性伴應進行追蹤、檢查和治療。
